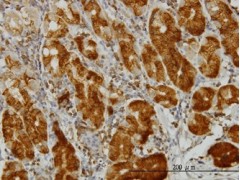

| 产品名称 | 产品编号 | 规格 | 单价 |
| Monoclonal Anti-PARP1 | AMAB90960 | 100μL | 4549.968 |
| Monoclonal Anti-Protein A antibody produced in mouse | P2921-100UL | 100μL | 4793.889 |
| Monoclonal Anti-Protein A antibody produced in mouse | P2921-0.2ML | 0.2ML | 6205.915 |
| Monoclonal Anti-LIN28 antibody produced in mouse | SAB4200413 | 200μL | 4657.837 |
| Monoclonal Anti-LIN28 antibody produced in mouse | SAB5300058 | 100μL | 3592.745 |
| Monoclonal Anti-CARS antibody produced in mouse | AMAB90972 | 100μL | 4549.968 |
| Monoclonal Anti-CARS antibody produced in mouse | AMAB90971 | 100μL | 4549.968 |
| Monoclonal Anti-CARS antibody produced in mouse | AMAB90973 | 100μL | 4549.968 |
| Monoclonal Anti-CARS antibody produced in mouse | AMAB90970 | 100μL | 4549.968 |
| Monoclonal Anti-EZR antibody produced in mouse | SAB1402391 | 100μG | 3592.745 |
| Monoclonal Anti-EZR antibody produced in mouse | AMAB90977 | 100μL | 4549.968 |
| Monoclonal Anti-EZR antibody produced in mouse | AMAB90979 | 100μL | 4549.968 |
| Monoclonal Anti-EZR antibody produced in mouse | AMAB90975 | 100μL | 4549.968 |
| Monoclonal Anti-EZR antibody produced in mouse | AMAB90976 | 100μL | 4549.968 |
| Monoclonal Anti-Acetylcholinesterase antibody produced in mouse | A6970-0.1ML | 0.1ML | 6119.425 |
| 单克隆抗-* 小鼠抗 | D8156-0.1ML | 0.1ML | 4793.889 |
| 单克隆抗-生物素 小鼠抗 | B7653 | 100μL | 3257.474 |
| 单克隆抗-生物素 小鼠抗 | B7653-0.2ML | 0.2ML | 4273.976 |
| Monoclonal Anti-LY6K antibody produced in mouse | AMAB90986 | 100μL | 4549.968 |
| Monoclonal Anti-LY6K antibody produced in mouse | AMAB90987 | 100μL | 4549.968 |
| Monoclonal Anti-GORASP2 antibody produced in mouse | AMAB90993 | 100μL | 4549.968 |
| Monoclonal Anti-GORASP2 antibody produced in mouse | AMAB91016 | 100μL | 4549.968 |
| Anti-CD28 antibody, Mouse monoclonal | C7831 | 100TEST | 3369.231 |
| Anti-Notch3 antibody, Rat monoclonal | SAB4200125 | 200μL | 3592.745 |
| 抗 α-微管蛋白单克隆抗体 小鼠抗 | T5168 | 100μL | 4793.889 |
| 抗 α-微管蛋白单克隆抗体 小鼠抗 | T5168-0.2ML | 0.2ML | 6205.915 |
| 抗 α-微管蛋白单克隆抗体 小鼠抗 | T5168-0.5ML | 0.5ML | 12410.86 |
| 抗 α-微管蛋白单克隆抗体 小鼠抗 | T9026 | 100μL | 3580.111 |
| 抗 α-微管蛋白单克隆抗体 小鼠抗 | T9026-0.2ML | 0.2ML | 6218.548 |
| 抗 α-微管蛋白单克隆抗体 小鼠抗 | T6074-100μL | 100μL | 4793.889 |
| 抗 α-微管蛋白单克隆抗体 小鼠抗 | T6074-200μL | 200μL | 5544.119 |
| Monoclonal Anti-FITC antibody produced in mouse | F5636-0.2ML | 0.2ML | 3728.797 |
| Monoclonal Anti-FITC antibody produced in mouse | F5636-0.5ML | 0.5ML | 4793.889 |
| Monoclonal Anti-CD8 antibody produced in mouse | SAB4701064 | 100μG | 3700.614 |
| Monoclonal Anti-CD8 antibody produced in mouse | SAB4700084 | 100μG | 2526.68 |
| Monoclonal Anti-CD8 antibody produced in mouse | SAB4700089 | 100μG | 2526.68 |
| Monoclonal Anti-CD8 antibody produced in mouse | C7423 | 100TEST | 3592.745 |
| 抗-*-FITC单克隆抗体 小鼠抗 | F3523-0.2ML | 0.2ML | 2006.767 |
| Monoclonal Anti- MAGE-11 | SAB4200158 | 200μL | 3592.745 |
| 抗 磷酸酪氨酸抗体,小鼠单克隆 | P5872-25μL | 25μL | 1472.277 |
| 抗 磷酸酪氨酸抗体,小鼠单克隆 | P5872 | 200μL | 3716.163 |
| 抗 磷酸酪氨酸抗体,小鼠单克隆 | P1869 | 200μL | 4581.065 |
| Monoclonal Anti-HNRNPC antibody produced in mouse | AMAB91010 | 100μL | 4549.968 |
| Monoclonal Anti-HNRNPC antibody produced in mouse | AMAB91012 | 100μL | 4549.968 |
| Monoclonal Anti-NOP56 antibody produced in mouse | AMAB91013 | 100μL | 4549.968 |
| Monoclonal Anti-CD4 antibody produced in mouse | SAB4700932 | 100μG | 3700.614 |
| Monoclonal Anti-CD4 antibody produced in mouse | SAB4700054 | 100μG | 2526.68 |
| Monoclonal Anti-CD4 antibody produced in mouse | C1805 | 100TEST | 3369.231 |
| Monoclonal Anti-CD4 antibody produced in mouse | SAB4700733 | 100μG | 2526.68 |
| Monoclonal Anti-CD4 antibody produced in mouse | AMAB90754 | 100μL | 4549.968 |
| 黏着斑蛋白单克隆抗体 小鼠抗 | V9131 | 100μL | 3580.111 |
| 黏着斑蛋白单克隆抗体 小鼠抗 | V9131-0.2ML | 0.2ML | 6218.548 |
| 黏着斑蛋白单克隆抗体 小鼠抗 | V4505 | 100μL | 3666.601 |
| 黏着斑蛋白单克隆抗体 小鼠抗 | V4505-0.2ML | 0.2ML | 4793.889 |
| Monoclonal Anti-HRP antibody produced in mouse | SAB4700977 | 100μG | 3700.614 |
| Monoclonal Anti-HRP antibody produced in mouse | SAB5300168 | 100μL | 3561.647 |
| Monoclonal Anti-TUFM antibody produced in mouse | WH0007284M1 | 100μG | 3480.988 |
| Monoclonal Anti-TUFM antibody produced in mouse | AMAB90964 | 100μL | 4549.968 |
| Monoclonal Anti-TUFM antibody produced in mouse | AMAB90965 | 100μL | 4549.968 |
| Monoclonal Anti-TUFM antibody produced in mouse | AMAB90966 | 100μL | 4549.968 |
| Monoclonal Anti-ABCD3 antibody produced in mouse | AMAB90995 | 100μL | 4549.968 |
| Monoclonal Anti-VPS26A antibody produced in mouse | AMAB90967 | 100μL | 4549.968 |
| Anti-Avidin antibody, Mouse monoclonal, biotin conjugate | B9655-0.5ML | 0.5ML | 2551.947 |
| MonOCLONAL ANTI-GLUCAGON antibody produced in mouse | G2654 | 100μL | 4793.889 |
| MonOCLONAL ANTI-GLUCAGON antibody produced in mouse | G2654-0.2ML | 0.2ML | 6205.915 |
| MonOCLONAL ANTI-GLUCAGON antibody produced in mouse | SAB4200685-25μL | 25μL | 1758.958 |
| MonOCLONAL ANTI-GLUCAGON antibody produced in mouse | SAB4200685 | 100μL | 4793.889 |
| MonOCLONAL ANTI-GLUCAGON antibody produced in mouse | SAB1305508 | 100μL | 4446.957 |
| Monoclonal Anti-PARP1 antibody produced in mouse | WH0000142M1 | 100μG | 4075.729 |
| Monoclonal Anti-PARP1 antibody produced in mouse | AMAB90959 | 100μL | 4549.968 |
| 单克隆抗-mCherry 小鼠抗 | SAB2702291 | 100μL | 5125.273 |
| 单克隆抗-mCherry 小鼠抗 | SAB2702295 | 100μL | 5071.824 |
| 单克隆抗-mCherry 小鼠抗 | SAB2702286 | 100μL | 5115.555 |
| 抗 CD4-小鼠单克隆 FITC 抗体 | F1773-50TEST | 50TEST | 2935.808 |
| 抗 CD4-小鼠单克隆 FITC 抗体 | F1773-100TEST | 100TEST | 3369.231 |
| 单克隆抗-生物素 | F4024-0.2ML | 0.2ML | 2366.333 |
| 抗-黏着斑蛋白抗体,小鼠单克隆抗体 | V9264-100μL | 100μL | 4793.889 |
| 抗-黏着斑蛋白抗体,小鼠单克隆抗体 | V9264-200μL | 200μL | 6205.915 |
| 抗-黏着斑蛋白抗体,小鼠单克隆抗体 | SAB4200080 | 200μL | 4483.885 |
| 抗-黏着斑蛋白抗体,小鼠单克隆抗体 | SAB4200729 | 100μL | 4793.889 |
| 单克隆抗 生物素 −过氧物酶 小鼠抗 | A0185 | 1VIAL | 3071.86 |
| Monoclonal Anti-CD3 antibody produced in mouse | SAB4700040 | 100μG | 1523.782 |
| Monoclonal Anti-CD3 antibody produced in mouse | SAB4701063 | 100μG | 3700.614 |
| Monoclonal Anti-CD3 antibody produced in mouse | SAB4700044 | 100μG | 2526.68 |
| Monoclonal Anti-CD3 antibody produced in mouse | SAB4700045 | 100μG | 2526.68 |
| Monoclonal Anti-CD3 antibody produced in mouse | SAB4700050 | 100μG | 2526.68 |
| Monoclonal Anti-PDIA3 antibody produced in mouse | AMAB90991 | 100μL | 4549.968 |
| Monoclonal Anti-PDIA3 antibody produced in mouse | AMAB90990 | 100μL | 4549.968 |
| Monoclonal Anti-PDIA3 antibody produced in mouse | AMAB90988 | 100μL | 4549.968 |
| 抗-LC3B抗体,小鼠单克隆 | SAB4200361 | 200μL | 4682.132 |
| 小鼠抗Cy5单克隆抗体 | C1117-25μL | 25μL | 1472.277 |
| 小鼠抗Cy5单克隆抗体 | C1117-100μL | 100μL | 3257.474 |
| 小鼠抗Cy5单克隆抗体 | C1117-200μL | 200μL | 4273.976 |
| Anti-DPP4/CD26 antibody, Mouse monoclonal | SAB4200230 | 200μL | 3592.745 |
| Anti-XPO4 antibody, Mouse monoclonal | SAB4200417 | 200μL | 3592.745 |
| Anti-PSMA antibody, Mouse monoclonal | SAB4200257 | 100μL | 3870.679 |
| Anti-TIN2 antibody, Mouse monoclonal | SAB4200108 | 200μL | 3592.745 |
| Anti-TIN2 antibody, Mouse monoclonal | SAB4200157 | 200μL | 3592.745 |
| 单克隆抗 神经酰胺 小鼠抗 | C8104 | 50TEST | 5473.178 |
| Monoclonal Anti-Phosphothreonine antibody produced in mouse | P3555 | 100μL | 3257.474 |
| Monoclonal Anti-Phosphothreonine antibody produced in mouse | P3555-0.2ML | 0.2ML | 4273.976 |
| Monoclonal Anti-Phosphothreonine antibody produced in mouse | P3555-0.5ML | 0.5ML | 5281.733 |
| Monoclonal Anti-Phosphothreonine antibody produced in mouse | P6623-100μL | 100μL | 3257.474 |
| Monoclonal Anti-Phosphothreonine antibody produced in mouse | P6623-200μL | 200μL | 4273.976 |
| Anti-PIWIL1 antibody, Mouse monoclonal | SAB4200365 | 200μL | 4682.132 |
| Anti-PIWIL1 antibody, Mouse monoclonal | SAB4200364 | 200μL | 4682.132 |
| Monoclonal Anti-CD3−PE antibody produced in mouse | SAB4700049 | 100TEST | 4037.829 |
| Monoclonal Anti-CD3−PE antibody produced in mouse | SAB4700051 | 100μG | 4037.829 |
| Monoclonal Anti-CD3−PE antibody produced in mouse | P5810 | 100TEST | 3369.231 |